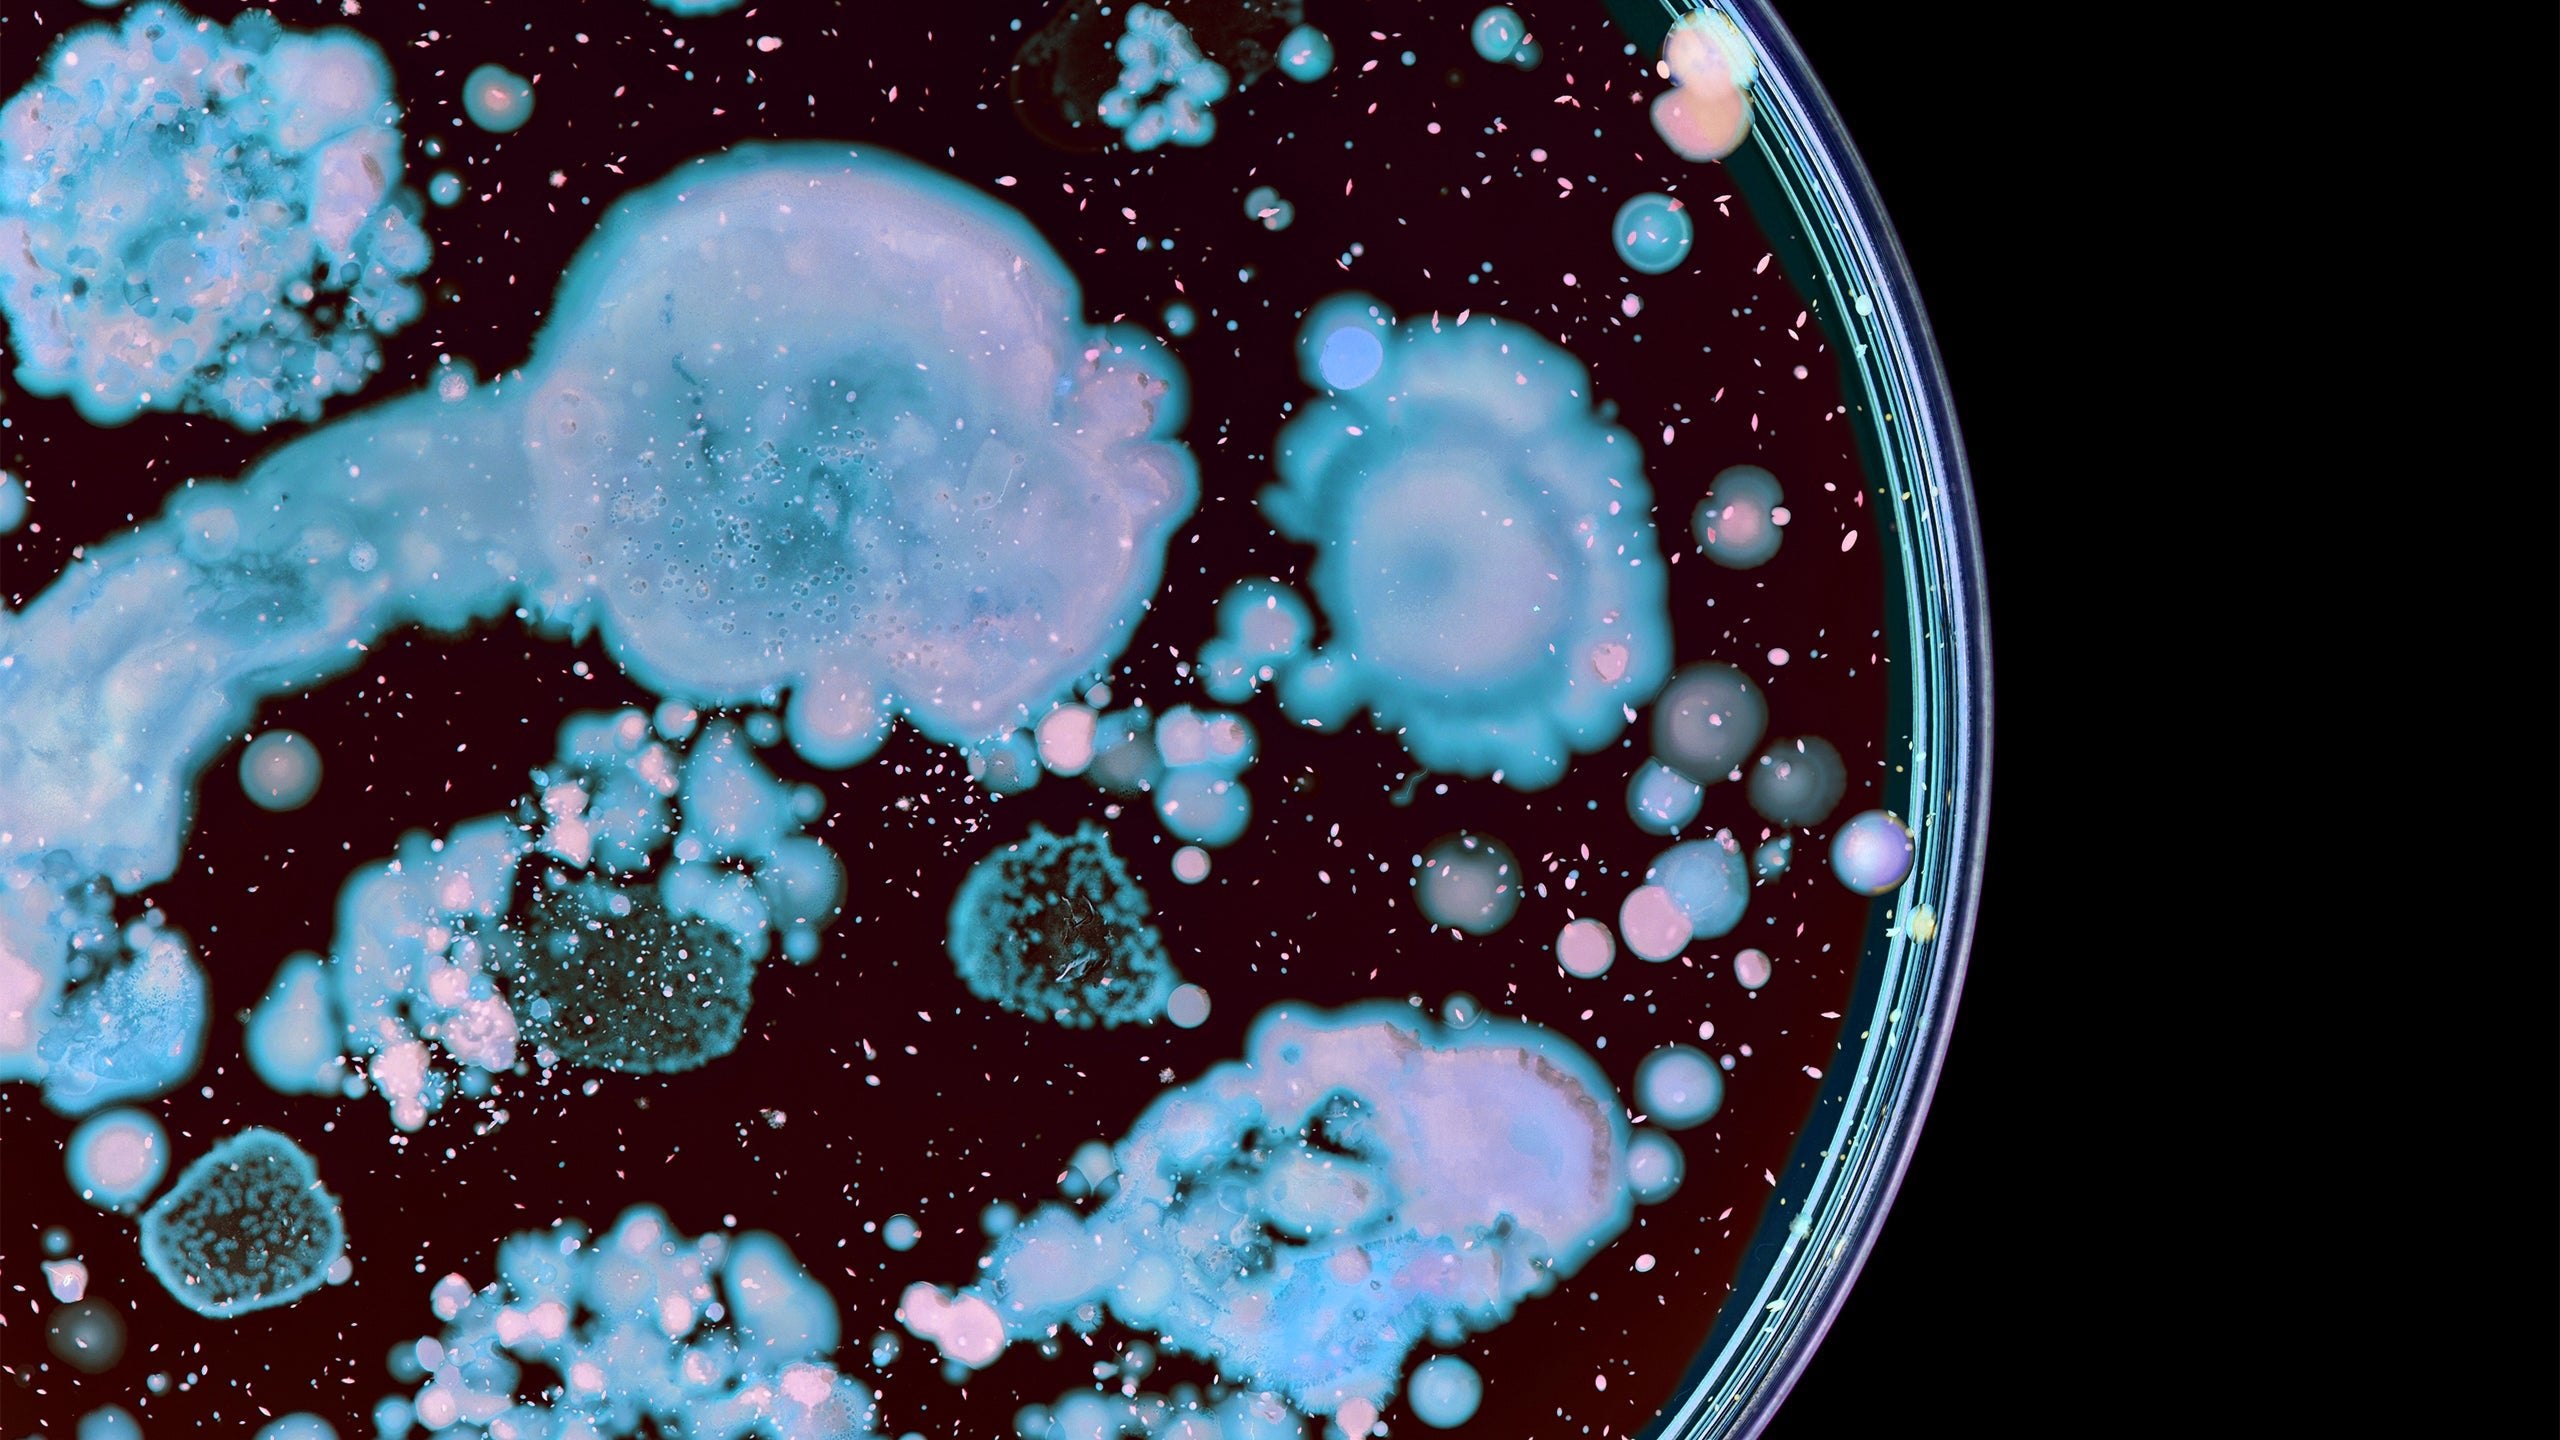
Your Guide to Probiotic Skin Care: Is It Worth the Hype - Gladskin

Is the key to a glowing complexion really bacteria?
Research linking acne, eczema, and rosacea to an imbalance in the skin microbiome — as well as the rising popularity of probiotic skincare — would suggest so.
But with hundreds of probiotic-containing serums and creams advertising the health benefits of the living microorganisms in them, you have to wonder: is it all marketing hype?
To answer that question, we’re covering what probiotic skincare is, how and if it works, and other ways to care for the beneficial bacteria living on your skin’s surface.
What Is Probiotic Skin Care?
Just like your gut, your skin is home to thousands of different bacteria. These good-for-you bacteria help to keep your skin hydrated, balance your skin pH, protect against environmental threats, and more. However, both good and bad bacteria live on the skin surface… and when the bad bacteria outweigh the good, skin troubles start to arise.
That’s where probiotic skincare comes in. Skincare products containing live bacteria have become an increasingly popular way to help fight against pesky skin conditions. These products are what’s referred to as probiotic skincare.
However, probiotic skin care isn’t the only form of ‘biotic’ care. There’s also prebiotic and postbiotic skin care… So what are those?
While probiotics are the live bacteria used to help rebalance the bacteria living on your skin, prebiotics are essentially the ‘food’ good bacteria thrive one.
That’s how prebiotics help support the growth of beneficial bacteria and deter the survival of the harmful bacteria.
Prebiotic skin care includes plant-based sugars and oils that provide nutrition for good bacteria on the skin.
On the other hand, postbiotics are the byproducts of living bacteria that contain metabolites — but not the living bacteria themselves. They’re a byproduct produced during the fermentation process of probiotics.
Lactic acid and glycerol are two examples of postbiotics that are included in many topical products today.
Do Probiotic Skin Care Products Work?
Right now, probiotic skincare products are in high demand. That doesn’t always mean they work, though. So, before you make a quick decision to purchase a pricey product, let’s deep dive into the effectiveness of probiotics for the skin.
First, it’s important to note that not all probiotic skincare products are created equal. In fact, it’s actually challenging to determine the quality of the products you’re purchasing. Not all ingredients labels will disclose the number of probiotics in your creams or serums. Nor do they ensure the probiotics’ ability to survive.
Because probiotics are living microorganisms, they can die… and they often do as a result of high temperatures or other environmental stressors. When probiotics die, they’re not helpful to you!
That just means loads of wasted money.
While knowing what quality and quantity of probiotics you’re purchasing in today’s market is almost impossible, there’s another root problem with probiotics for the skin: the type.
Many topical probiotic products on the market today contain probiotic strains that aren’t even naturally occurring on the skin surface.
Not all probiotics that are good for the gut are also good for the skin, and it's important to know that if you use products with live probiotics on the skin, that they are beneficial to the skin.
Many companies use commercially available probiotics made for gut health and put them in skin care products just to be able to make the 'probiotic' claim and take advantage of the current hype around probiotic skincare products.
So, are probiotic products worth the hype? We’d say most of the time, no.
Other Ways to Balance Your Skin Microbiome
If you’re not willing to take the risk of trying out expensive probiotic products for your skin, don’t fret. There are plenty of other ways, including lifestyle changes, to help rebalance the bacteria in your skin microbiome.
Spend time outside
Soil represents one of the most diverse ecosystems on the planet. It houses a vast array of bacteria, viruses, fungi, archaea, and protozoa.
One study shows how exposure to such diversity can positively impact human health. When participants dug in the dirt, touched the plants, and breathed in the air in urban green spaces, the diversity of their skin microbiomes significantly increased.
Avoid over-cleansing
When you over-shower and over-cleanse, you can strip your skin of healthy oils and harm your skin microbiome. Most of us shower with drying soaps in hot water for an extended amount of time (because who doesn’t love a hot shower?).
As enjoyable as long, hot showers can be, it’s better to take shorter showers and use lukewarm water to help preserve the healthy bacteria on your skin. You’ll also want to swap out your harsh soaps with a soap-free alternative like this gentle body wash for sensitive skin that allows your skin microbiome to thrive.
Apply Gladskin Eczema Cream
Just like with probiotic skincare, Gladskin Eczema Cream helps to rebalance your skin microbiome. It uses our patented smart protein, Micreobalance®, that works with your body to restore balance to the skin microbiome gently and effectively while moisturizing at the same time.
While Gladskin Eczema Cream doesn’t contain those live beneficial bacteria, it works to balance the skin bacteria while moisturizing. Balance means the harmful bacteria will have a hard time multiplying, and the good guys will do better.
It’s free of steroids, fragrances, drying alcohols, preservatives, parabens, and sulfates that can irritate and dry out the skin. So, if you’ve been considering probiotic skincare to help with a skin concern such as eczema, this may be a beneficial alternative solution.
Four out of five Gladskin Eczema Cream users experience significantly reduced itch and redness associated with eczema.
Conclusion
Probiotic skincare products are supposed to target an imbalance in the skin microbiome to restore the appearance and hydration of the skin. However, it’s almost impossible to verify the quality and quantity of probiotic products you’re purchasing. You could be paying for dead or potentially unhelpful probiotics!
Not to mention that not all probiotic strains are helpful when applied to the skin surface….
That’s why we recommend incorporating microbiome-balancing lifestyle changes into your diet and incorporating tried-and-true microbiome-balancing creams like Gladskin Eczema Cream into your skincare routine.